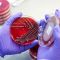
الرئيسية 9 الإصابات الجرثومية لعمال نقل النفايات في المكبات العامة

| الطاهر الثابت | أخبار
حوارية بعنوان “المخلفات الطبية والطرق الصحيحة للتخلص منها”
في إطار فعاليات اليوم الثاني لملتقى صيادلة بلا حدود، نظمت اللجنة المنظمة حوارية متخصصة بعنوان “المخلفات الطبية والطرق الصحيحة للتخلص منها”، والتي هدفت إلى تسليط الضوء على أهم الممارسات الآمنة للتخلص…
توعية
كمية الكمامات الطبية المستهلكة يومياً في بعض الدول الأسيوية والعربية وعلاقتها بكمية النفايات الطبية
كانت ولا زالت معدات وملابس الوقاية الشخصية والتي من ضمنها الكمامات الطبية (Medi…
| الطاهر الثابت | التشريعات البيئية, الكوارث البيئية, الجرائم البيئية | لا توجد تعليقات على هل يجب على الدول الأفريقية تشديد قوانينها البيئية فيما يخص استيراد النفايات الخطرة؟
هل يجب على الدول الأفريقية تشديد قوانينها البيئية فيما يخص استيراد النفايات الخطرة؟
| الطاهر الثابت | منوعات, التشريعات البيئية, إدارة النفايات الرعاية الصحية, توعية | لا توجد تعليقات على دور المجتمع المدني والقطاع الخاص في تعزيز إدارة النفايات الطبية
دور المجتمع المدني والقطاع الخاص في تعزيز إدارة النفايات الطبية
يلعب المجتمع المدني والقطاع الخاص أدوارًا حيوية في تعزيز إدارة النفايات الطبية، وذلك من خلال المساهمة في تطوير السياسات، وزيادة الوعي، وتوفير التقنيات والموارد اللازمة. وفيما يلي أبرز الأدوار التي ي…
| الطاهر الثابت | منوعات, التشريعات البيئية | لا توجد تعليقات على جهود منظمة السلام الأخضر وشبكة عمل بازل بكشف حالات التخلص غير القانوني من النفايات ودعم الجهود المحلية لمكافحتها.
جهود منظمة السلام الأخضر وشبكة عمل بازل بكشف حالات التخلص غير القانوني من النفايات ودعم الجهود المحلية لمكافحتها.
منظمتا السلام الأخضر (Greenpeace) وشبكة عمل بازل (Basel Action Network – BAN) تلعبان أدوارًا مهمة في كشف حالات التخلص غير القانوني من النفايات الخطرة، بما في ذلك النفايات الطبية، ودع…
| الطاهر الثابت | منوعات, التشريعات البيئية, إدارة النفايات الرعاية الصحية, توعية | لا توجد تعليقات على دور المجتمع المدني والقطاع الخاص في تعزيز إدارة النفايات الطبية
دور المجتمع المدني والقطاع الخاص في تعزيز إدارة النفايات الطبية
يلعب المجتمع المدني والقطاع الخاص أدوارًا حيوية في تعزيز إدارة النفايات الطبية، وذلك من خلال المساهمة في تطوير السياسا…
| الطاهر الثابت | منوعات, التشريعات البيئية | لا توجد تعليقات على جهود منظمة السلام الأخضر وشبكة عمل بازل بكشف حالات التخلص غير القانوني من النفايات ودعم الجهود المحلية لمكافحتها.
جهود منظمة السلام الأخضر وشبكة عمل بازل بكشف حالات التخلص غير القانوني من النفايات ودعم الجهود المحلية لمكافحتها.
منظمتا السلام الأخضر (Greenpeace) وشبكة عمل بازل (Basel Action Network – BAN) تلعبان أدوارًا مهمة في ك…
الأكثر قراءة
-
حوارية بعنوان “المخلفات الطبية والطرق الصحيحة للتخلص منها”
-
بقاء الكائنات الحية الدقيقة المسببة للأمراض في البيئة
-
الإصابات الجرثومية لعمال نقل النفايات في المكبات العامة
-
التخلص من النفايات المشعة في مدافن جيولوجية عميقة
-
ما هي طرق التخلص النهائي من النفايات المشعة الناتجة من أقسام الطب النووي؟
-
المخاطر من النفايات السامة للجينات
المخلفات الطبية الحادة
الخصائص الفيزيوكيميائية لنفايات الرعاية الصحية الخطرة
نفايات الرعاية الصحية الخطرة تتميز بخصائص فيزيوكيميائية تجعلها مصدرًا للخطر على الصحة العامة والبيئة إذا لم يتم إدارتها بشكل صحيح. هذه الخصائص تعتمد على نوع النفايات ومصدرها. فيما يلي نظرة عامة على…
المخلفات الطبية الحادة
المخلفات الطبية المعدية
بقاء الكائنات الحية الدقيقة المسببة للأمراض في البيئة
بقاء الكائنات الحية الدقيقة المسببة للأمراض في البيئة هو عامل حاسم في انتقال الأمراض المعدية. تشمل هذه الكائنات البكتي…
الإصابات الجرثومية لعمال نقل النفايات في المكبات العامة
إصابة عمال نقل النفايات في المكبات العامة بالعدوى الجرثومية (البكتيرية) يُعتبر خطرًا صحيًا كبيرًا بسبب تعرضهم المباشر…
الخصائص الفيزيوكيميائية لنفايات الرعاية الصحية الخطرة
نفايات الرعاية الصحية الخطرة تتميز بخصائص فيزيوكيميائية تجعلها مصدرًا للخطر على الصحة العامة والبيئة إذا لم يتم إدارته…
لماذا يجب علينا التخلص السليم من النفايات المحتوية الكائنات الدقيقة وبقايا النباتات المعدلة جينية؟
التخلص السليم من النفايات المحتوية على الكائنات الدقيقة وبذور النباتات المعدلة جينياً (GMOs) هو أمر بال…
الخصائص الفيزيوكيميائية لنفايات الرعاية الصحية الخطرة
نفايات الرعاية الصحية الخطرة تتميز بخصائص فيزيوكيميائية تجعلها مصدرًا للخطر على الصحة العامة والبيئة إذا لم يتم إدارتها بشكل صحيح. هذه الخصائص تعتمد على نوع النفايات ومصدرها. فيما يلي نظرة عامة على الخصائص الفيزيوكيميائية الرئيسية لنفايات الرعاية ا…
| الطاهر الثابت | المخلفات الطبية الباثولوجية, المخلفات الطبية المعدية, إدارة النفايات الرعاية الصحية | لا توجد تعليقات على النفايات الطبية بمستشفيات جراحة الحروق والتجميل
النفايات الطبية بمستشفيات جراحة الحروق والتجميل
النفايات الطبية في مستشفى جراحة الحروق والتجميل تتطلب إدارة دقيقة نظرًا لطبيعة الرعاية المقدمة في هذه المستشفيات. مستشفيات الحروق والتجميل تنتج مجموعة متنوعة من النفايات الطبية التي قد تكون خطيرة إذ…
| الطاهر الثابت | المخلفات الطبية الباثولوجية, المرافق الصحية, معالجة النفايات الطبية, إدارة النفايات الرعاية الصحية | لا توجد تعليقات على حفرة دفن للنفايات الطبية التشريحية
حفرة دفن للنفايات الطبية التشريحية
حفرة الدفن للنفايات الطبية التشريحية هي طريقة تقليدية للتخلص من هذا النوع من النفايات في المناطق التي تفتقر إلى البنية التحتية اللازمة لطرق التخلص الأكثر تطوراً، مثل التعقيم بالبخار. وتحتاج هذه العم…
| الطاهر الثابت | أخبار, المخلفات الطبية الباثولوجية, المرافق الصحية, إدارة النفايات الرعاية الصحية, مياه الصرف الصحي | لا توجد تعليقات على الملوثات العضوية من المستشفيات
الملوثات العضوية من المستشفيات
الملوثات العضوية من المستشفيات تشمل مجموعة متنوعة من المواد التي قد تكون ضارة بالبيئة والصحة العامة إذا لم تتم إدارتها بشكل صحيح. هذه المل…
| الطاهر الثابت | المخلفات الطبية المعدية, المخلفات الطبية الباثولوجية, المخلفات الطبية البيطرية, إدارة النفايات الرعاية الصحية | تعليقين على مرض فيروس جدري القرود وإدارة النفايات الطبية
مرض فيروس جدري القرود وإدارة النفايات الطبية
إدارة النفايات الطبية بشكل صحيح عند التعامل مع حالات فيروس جدري القرود أمر بالغ الأهمية للحفاظ على الصحة العامة ومنع انتشار الفيروس. يمكن…
| الطاهر الثابت | المخلفات الطبية المعدية, المخلفات الطبية الباثولوجية, توعية | لا توجد تعليقات على نمو وبقاء الكائنات المُمْرِضة في النفايات الطبية أثناء التخزين
نمو وبقاء الكائنات المُمْرِضة في النفايات الطبية أثناء التخزين
النفايات الطبية تُعد مصدرًا كبيرًا للقلق عندما يتعلق الأمر بانتشار الكائنات المُمْرِضة. الكائنات المُمْرِضة مثل البكتيريا والفيروسات والطف…
| الطاهر الثابت | المخلفات الطبية الباثولوجية, المخلفات الطبية المعدية | لا توجد تعليقات على النفايات الباثولوجية: كيف يتم التخلص من الدهون بعد عملية شفط الدهون؟
النفايات الباثولوجية: كيف يتم التخلص من الدهون بعد عملية شفط الدهون؟
من أكثر أنواع النفايات الطبية الناتجة عن الخذمات الرعاية الصحية، والتي يوجد تحسس عام لها وعدم قبول العبث بها هي النفايات الباثولوجية (يطلق…
الخصائص الفيزيوكيميائية لنفايات الرعاية الصحية الخطرة
نفايات الرعاية الصحية الخطرة تتميز بخصائص فيزيوكيميائية تجعلها مصدرًا للخطر على الصحة العامة والبيئة إذا لم يتم إدارتها بشكل صحيح. هذه الخصائص تعتمد على نوع النفايات ومصدرها. فيما يلي نظرة عامة على…
النفايات الطبية البيطرية وإسطبلات ومراكز تربية ال…
النفايات الطبية الناتجة عن الرعاية البيطرية وتربية الخيول تشمل أنواعًا متنوعة…
إدارة النفايات الطبية البيطرية الطارئة خلال حالات…
إدارة النفايات الطبية البيطرية الطارئة خلال حالات الأوبئة أمر حيوي للحفاظ على…
كيفية تقليل النفايات الطبية البيطرية؟
تقليل النفايات البيطرية في محطات تربية الحيوانات هو خطوة هامة لتحسين الأداء ال…
المخلفات الصيدلانية
الطاهر الثابت
كيف نحد من انتشار السلالات المقاومة للأدوية خلال الصناعات الدوائية؟
الحد من انتشار السلالات الجرثومية المقاومة للأدوية في الصناعات الدوائية يتطلب اتباع إجراءات صارمة على مستوى تصنيع الأدوية، توزيعها، استخدامها، والتخلص منها. الصناعات الدوائية تلعب دورًا كبيرًا في ضم…
معالجة مياه الصرف الصحي في مصانع الأدوية
معالجة مياه الصرف الصحي في مصانع الأدوية تعتبر خطوة حيوية لضمان تقليل التأثير السلبي للنفايات الدوائية على البيئة والمصادر المائية. تحتوي م…
مراقبة آثار الأدوية على البيئة
مراقبة آثار الأدوية على البيئة هي عملية مهمة لضمان حماية النظم البيئية وصحة الإنسان من الآثار السلبية التي قد تنتج عن تسرب الأدوية أو مكونا…
تقييم الأثر البيئي في الصناعات الدوائية
تقييم الأثر البيئي (Environmental Impact Assessment – EIA) في الصناعات الدوائية هو عملية تهدف إلى دراسة وتحليل الآثار البيئية المحتمل…
النفايات الصيدلانية والتأثير على التنوع البيولوجي
النفايات الصيدلانية يمكن أن تؤثر بشكل كبير على التنوع البيولوجي، حيث تحتوي على مواد كيميائية نشطة مثل المضادات الحيوية، الهرمونات، والمسكنا…
فرض رقابة صارمة على عمليات التخلص من النفايات الصيدلانية
فرض رقابة صارمة على عمليات التخلص من النفايات الصيدلانية هو إجراء حيوي لحماية الصحة العامة والبيئة ومنع انتشار السلالات البكتيرية المقاومة…
تقييم الأثر البيئي في الصناعات الدوائية
النفايات الصيدلانية والتأثير على التنوع البيولوجي
فرض رقابة صارمة على عمليات التخلص من النفايات الصيدلانية
هل يمكن التخلص من النفايات الصيدلانية (الأدوية) بواسطة الصر…
خطورة التخلص من النفايات الصيدلانية في المراحيض وأحواض الحم…
| الطاهر الثابت | مخلفات العلاج الكيماوي, المخلفات الكيميائية | لا توجد تعليقات على المخاطر من النفايات السامة للجينات
المخاطر من النفايات السامة للجينات
النفايات السامة للجينات (Genotoxic Waste) هي نوع من النفايات الخطرة التي تحتوي على مواد قادرة على إتلاف الحمض النووي (DNA) في الخلايا، مما قد يؤدي إلى طفرات جينية، سرطان، أو تشوه…
| الطاهر الثابت | المخلفات الطبية الحادة, المخلفات الطبية المعدية, المخلفات الطبية الباثولوجية, المخلفات الطبية البيطرية, مخلفات العلاج الكيماوي, المخلفات الكيميائية, إدارة النفايات الرعاية الصحية | لا توجد تعليقات على الخصائص الفيزيوكيميائية لنفايات الرعاية الصحية الخطرة
الخصائص الفيزيوكيميائية لنفايات الرعاية الصحية الخطرة
| الطاهر الثابت | مخلفات العلاج الكيماوي, المخلفات الكيميائية | لا توجد تعليقات على المخاطر من النفايات السامة للجينات
المخاطر من النفايات السامة للجينات
النفايات السامة للجينات (Genotoxic Waste) هي نوع من النفايات الخطرة التي تحتوي على مواد قادرة على إتلاف الحمض النووي (…
| الطاهر الثابت | المخلفات الطبية الحادة, المخلفات الطبية المعدية, المخلفات الطبية الباثولوجية, المخلفات الطبية البيطرية, مخلفات العلاج الكيماوي, المخلفات الكيميائية, إدارة النفايات الرعاية الصحية | لا توجد تعليقات على الخصائص الفيزيوكيميائية لنفايات الرعاية الصحية الخطرة
الخصائص الفيزيوكيميائية لنفايات الرعاية الصحية الخطرة
نفايات الرعاية الصحية الخطرة تتميز بخصائص فيزيوكيميائية تجعلها مصدرًا للخطر على الصحة العامة والبيئة إذا لم يتم إدارته…
| الطاهر الثابت | المخلفات الطبية المشعة | لا توجد تعليقات على التخلص من النفايات المشعة في مدافن جيولوجية عميقة
التخلص من النفايات المشعة في مدافن جيولوجية عميقة
التخلص من النفايات المشعة في مدافن جيولوجية عميقة (Deep Geological Repositories) يُعتبر أحد أكثر الطرق…
| الطاهر الثابت | المخلفات الطبية المشعة | لا توجد تعليقات على ما هي طرق التخلص النهائي من النفايات المشعة الناتجة من أقسام الطب النووي؟
ما هي طرق التخلص النهائي من النفايات المشعة الناتجة من أقسام الطب النووي؟
التخلص النهائي من النفايات المشعة الناتجة من أقسام الطب النووي يتطلب إجراءات دقيقة ومُحكمة لضمان السلامة العامة وحماية…
تخزين النفايات المشعة بالمستشفيات
هناك العديد من المستشفيات لديها أقسام للطب النووي (Nuclear Medicine) وهم متخصصين في استخدام المواد المشعة لتشخيص ومعال…
| الطاهر الثابت | المخلفات الطبية المشعة | لا توجد تعليقات على تعليمات خاصة بالنفايات الطبية المشعة في المرافق الصحية
تعليمات خاصة بالنفايات الطبية المشعة في المرافق الصحية
تستخدم المستشفيات الكبرى ومرافق الرعاية الصحية المواد المشعة في العديد من الإجراءات التشخيصية والعلاجية والبحثية، إذا…
| الطاهر الثابت | المرافق الصحية, إدارة النفايات الرعاية الصحية, توعية | لا توجد تعليقات على الأشخاص المعرضون لخطر النفايات الرعاية الصحية
الأشخاص المعرضون لخطر النفايات الرعاية الصحية
نفايات الرعاية الصحية الخطرة تشكل تهديدًا كبيرًا لصحة وسلامة العديد من الأفراد، خاصة أولئك الذين يتعاملون معها مباشرة…
| الطاهر الثابت | إدارة النفايات الرعاية الصحية, المرافق الصحية | لا توجد تعليقات على توصيات لتقليل التكلفة في إدارة النفايات الرعاية الصحية
توصيات لتقليل التكلفة في إدارة النفايات الرعاية الصحية
تقليل تكلفة إدارة نفايات الرعاية الصحية يُعد تحديًا كبيرًا للمنشآت الصحية، خاصة مع زيادة كميات النفايات وارتفاع تكاليف…
| الطاهر الثابت | مكافحة العدوى, المرافق الصحية, منوعات | لا توجد تعليقات على عزل المرضى المصابين بأمراض معدية لمنع انتشار العدوى
عزل المرضى المصابين بأمراض معدية لمنع انتشار العدوى
عزل المرضى المصابين بأمراض معدية هو إجراء وقائي يُستخدم لمنع انتشار العدوى داخل المستشفيات أو المؤسسات الصحية. يتم تطب…
| الطاهر الثابت | إدارة النفايات الرعاية الصحية, المرافق الصحية, مكافحة العدوى | لا توجد تعليقات على نظافة المستشفيات ومكافحة العدوى وإدارة النفايات الطبية
نظافة المستشفيات ومكافحة العدوى وإدارة النفايات الطبية
نظافة المستشفيات ومكافحة العدوى وإدارة النفايات الطبية هي عناصر ثلاثة حاسمة لضمان سلامة المرضى والعاملين في القطاع الص…